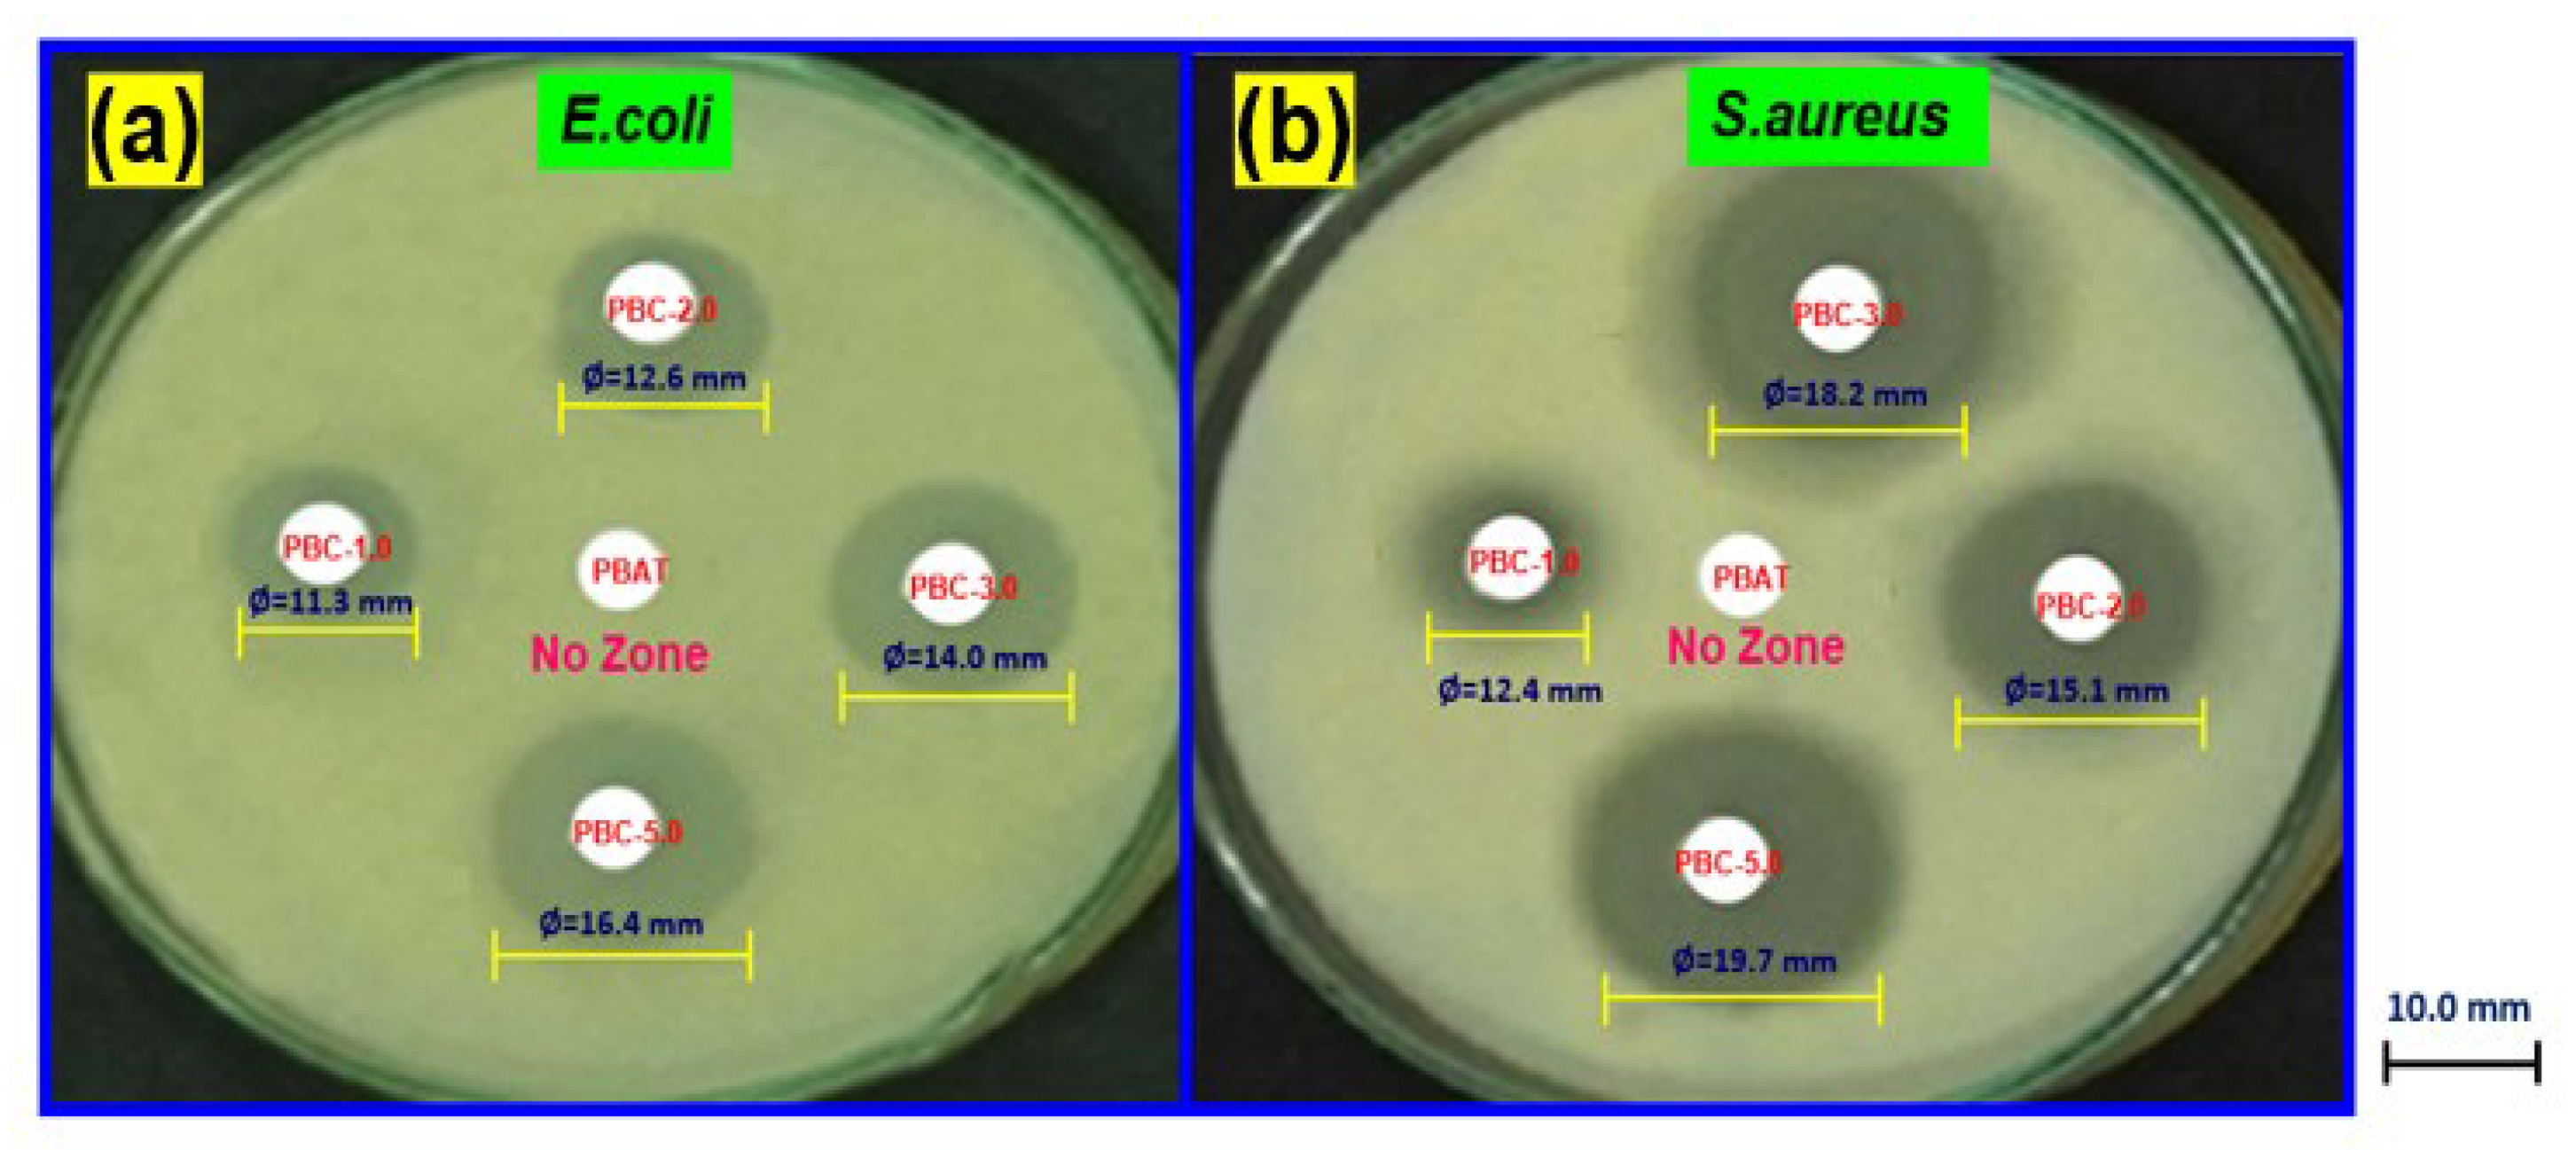
Polymers 15 01710 g006

Preparation and Antimicrobial Characterization of Poly(butylene adipate-co-terephthalate)/Kaolin Clay Biocomposites
Abstract
:1. Introduction
2. Materials and Methods
2.1. Materials
2.2. Preparation of PBAT/Kaolin Clay Composites
2.3. Characterization
2.3.1. Structural Characterization
2.3.2. Morphological Studies
2.3.3. Thermogravimetric Analysis (TGA)
2.3.4. Mechanical Properties
2.3.5. Barrier Properties
2.3.6. Measurements of the Contact Angle
2.3.7. Antimicrobial Property Measurements
2.3.8. Statistical Analysis
3. Results and Discussion
3.1. Characterization of Structural and Morphological Analysis
3.2. Thermal Characterization of PBAT/Kaolin Clay Composites
3.3. Characterization of Mechanical and Barrier Properties
3.4. Water Contact Angle Measurement
3.5. Antimicrobial Activities of PBAT/Kaolin Clay Composites
4. Conclusions
Author Contributions
Funding
Institutional Review Board Statement
Data Availability Statement
Conflicts of Interest
References
- Oshani, B.N.; Davachi, S.M.; Hejazi, I.; Seyfi, J.; Khonakdar, H.A.; Abbaspourrad, A. Enhanced compatibility of starch with poly(lactic acid) and poly(ɛ-caprolactone) by incorporation of POSS nanoparticles: Study on thermal properties. Int. J. Biol. Macromol. 2019, 141, 578–584. [Google Scholar] [CrossRef] [PubMed]
- Rammak, T.; Boonsuk, P.; Kaewtatip, K. Mechanical and barrier properties of starch blend films enhanced with kaolin for ap-plication in food packaging. Int. J. Biol. Macromol. 2021, 192, 1013–1020. [Google Scholar] [CrossRef] [PubMed]
- Castillo, L.; López, O.; López, C.; Zaritzky, N.; García, M.A.; Barbosa, S.; Villar, M. Thermoplastic starch films reinforced with talc nanoparticles. Carbohydr. Polym. 2013, 95, 664–674. [Google Scholar] [CrossRef] [PubMed]
- Romani, V.P.; Martins, V.G.; Goddard, J.M. Radical scavenging polyethylene films as antioxidant active packaging materials. Food Control 2020, 109, 106946. [Google Scholar] [CrossRef]
- Shaikh, S.; Yaqoob, M.; Aggarwal, P. An overview of biodegradable packaging in food industry. Curr. Res. Food Sci. 2021, 4, 503–520. [Google Scholar] [CrossRef]
- Bangar, S.P.; Whiteside, W.S.; Ashogbon, A.O.; Kumar, M. Recent advances in thermoplastic starches for food packaging: A review. Food Packag. Shelf Life 2021, 30, 100743. [Google Scholar] [CrossRef]
- Khalid, M.Y.; Arif, Z.U. Novel biopolymer-based sustainable composites for food packaging applications: A narrative review. Food Packag. Shelf Life 2022, 33, 100892. [Google Scholar] [CrossRef]
- Arrieta, M.P.; López, J.; Hernández, A.; Rayón, E. Ternary PLA–PHB–Limonene blends intended for biodegradable food packaging applications. Eur. Polym. J. 2014, 50, 255–270. [Google Scholar] [CrossRef]
- Yadav, M. Study on thermal and mechanical properties of cellulose/iron oxide bionanocomposites film. Compos. Commun. 2018, 10, 1–5. [Google Scholar] [CrossRef]
- Venkatesan, R.; Rajeswari, N. Nanosilica-reinforced poly(butylene adipate-co-terephthalate) nanocomposites: Preparation, characterization and properties. Polym. Bull. 2019, 76, 4785–4801. [Google Scholar] [CrossRef]
- Guo, G.; Zhang, C.; Du, Z.; Zou, W.; Tian, H.; Xiang, A.; Li, H. Structure and property of biodegradable soy protein isolate/PBAT blends. Ind. Crop. Prod. 2015, 74, 731–736. [Google Scholar] [CrossRef]
- Leporatti, S. Polymer Clay Nano-composites. Polymers 2019, 11, 1445. [Google Scholar] [CrossRef] [Green Version]
- Venkatesan, R.; Zhang, Y.; Chen, G. Preparation of poly(butylene adipate-co-terephthalate)/ZnSnO3 composites with enhanced antimicrobial activity. Compos. Commun. 2020, 22, 100469. [Google Scholar] [CrossRef]
- Arumugam, S.; Kandasamy, J.; Thiyaku, T.; Saxena, P. Effect of Low Concentration of SiO2 Nanoparticles on Grape Seed Essential Oil/PBAT Composite Films for Sustainable Food Packaging Application. Sustainability 2022, 14, 8073. [Google Scholar] [CrossRef]
- Jaramillo, A.F.; Riquelme, S.A.; Sánchez-Sanhueza, G.; Medina, C.; Solís-Pomar, F.; Rojas, D.; Montalba, C.; Melendrez, M.F.; Pérez-Tijerina, E. Comparative Study of the Antimicrobial Effect of Nanocomposites and Composite Based on Poly(butylene adipate-co-terephthalate) Using Cu and Cu/Cu2O Nanoparticles and CuSO4. Nanoscale Res. Lett. 2019, 14, 158. [Google Scholar] [CrossRef] [Green Version]
- Ibrahim, I.D.; Hamam, Y.; Sadiku, E.R.; Ndambuki, J.M.; Kupolati, W.K.; Jamiru, T.; Eze, A.A.; Snyman, J. Need for Sustainable Packaging: An Overview. Polymers 2022, 14, 4430. [Google Scholar] [CrossRef] [PubMed]
- Sid, S.; Mor, R.S.; Kishore, A.; Sharanagat, V.S. Bio-sourced polymers as alternatives to conventional food packaging materials: A review. Trends Food Sci. Technol. 2021, 115, 87–104. [Google Scholar] [CrossRef]
- Siracusa, V.; Rocculi, P.; Romani, S.; Rosa, M.D. Biodegradable polymers for food packaging: A review. Trends Food Sci. Technol. 2008, 19, 634–643. [Google Scholar] [CrossRef]
- Dammak, M.; Fourati, Y.; Tarrés, Q.; Delgado-Aguilar, M.; Mutjé, P.; Boufi, S. Blends of PBAT with plasticized starch for packaging applications: Mechanical properties, rheological behaviour and biodegradability. Ind. Crop. Prod. 2020, 144, 112061. [Google Scholar] [CrossRef]
- Lackner, M.; Ivanič, F.; Kováčová, M.; Chodák, I. Mechanical properties and structure of mixtures of poly(butylene-adipate-co-terephthalate) (PBAT) with thermoplastic starch (TPS). Int. J. Biobased Plast. 2021, 3, 126–138. [Google Scholar] [CrossRef]
- Tsou, C.-H.; Chen, Z.-J.; Yuan, S.; Ma, Z.-L.; Wu, C.-S.; Yang, T.; Jia, C.-F.; De Guzman, M.R. The preparation and performance of poly(butylene adipate) terephthalate/corn stalk composites. Curr. Res. Green Sustain. Chem. 2022, 5, 100329. [Google Scholar] [CrossRef]
- Wang, X.; Cui, L.; Fan, S.; Li, X.; Liu, Y. Biodegradable Poly(butylene adipate-co-terephthalate) Antibacterial Nanocomposites Reinforced with MgO Nanoparticles. Polymers 2021, 13, 507. [Google Scholar] [CrossRef] [PubMed]
- Zhong, Y.; Godwin, P.; Jin, Y.; Xiao, H. Biodegradable polymers and green-based antimicrobial packaging materials: A mini-review. Adv. Ind. Eng. Polym. Res. 2020, 3, 27–35. [Google Scholar] [CrossRef]
- Díez-Pascual, A.M.; Díez-Vicente, A.L. Antimicrobial and sustainable food packaging based on poly(butylene adipate-co-terephthalate) and electrospun chitosan nanofibers. RSC Adv. 2015, 5, 93095–93107. [Google Scholar] [CrossRef]
- Jamróz, E.; Kulawik, P.; Kopel, P. The Effect of Nanofillers on the Functional Properties of Biopolymer-Based Films: A Review. Polymers 2019, 11, 675. [Google Scholar] [CrossRef] [PubMed] [Green Version]
- Jafarzadeh, S.; Jafari, S.M. Impact of metal nanoparticles on the mechanical, barrier, optical and thermal properties of biodegradable food packaging materials. Crit. Rev. Food Sci. Nutr. 2021, 61, 2640–2658. [Google Scholar] [CrossRef]
- Rhim, J.-W.; Wang, L.-F. Preparation and characterization of carrageenan-based nanocomposite films reinforced with clay mineral and silver nanoparticles. Appl. Clay Sci. 2014, 97–98, 174–181. [Google Scholar] [CrossRef]
- Chausali, N.; Saxena, J.; Prasad, R. Recent trends in nanotechnology applications of bio-based packaging. J. Agric. Food Res. 2022, 7, 100257. [Google Scholar] [CrossRef]
- Lee, Y.H.; Kuboki, T.; Park, C.B.; Sain, M.; Kontopoulou, M. The effects of clay dispersion on the mechanical, physical, and flame-retarding properties of wood fiber/polyethylene/clay nanocomposites. J. Appl. Polym. Sci. 2020, 118, 452–461. [Google Scholar] [CrossRef]
- Powell, C.E.; Beall, G.W. Physical Properties of Polymer/Clay Nanocomposites. In Physical Properties of Polymers Handbook; Springer: New York, NY, USA, 2007; pp. 561–575. [Google Scholar] [CrossRef]
- Hu, L.; Leclair, E.; Poulin, M.; Colas, F.; Baldet, P.; Vuillaume, P.Y. Clay/Polyethylene Composites with Enhanced Barrier Properties for Seed Storage. Polym. Polym. Compos. 2016, 24, 387–394. [Google Scholar] [CrossRef]
- Muthuraj, R.; Misra, M.; Defersha, F.; Mohanty, A.K. Influence of processing parameters on the impact strength of biocomposites: A statistical approach. Compos. Part A Appl. Sci. Manuf. 2016, 83, 120–129. [Google Scholar] [CrossRef] [Green Version]
- Bhattacharyya, K.G.; Gupta, S.S. Adsorption of a few heavy metals on natural and modified kaolinite and montmorillonite: A review. Adv. Colloid Interface Sci. 2008, 140, 114–131. [Google Scholar] [CrossRef]
- Huang, M.; Wang, H.; Yu, J. Studies of biodegradable thermoplastic amylose/kaolin composites: Fabrication, characterization, and properties. Polym. Compos. 2006, 27, 309–314. [Google Scholar] [CrossRef]
- Jafarzadeh, S.; Alias, A.K.; Ariffin, F.; Mahmud, S.; Najafi, A. Preparation and characterization of bionanocomposite films reinforced with nano kaolin. J. Food Sci. Technol. 2016, 53, 1111–1119. [Google Scholar] [CrossRef] [Green Version]
- Venkatesan, R.; Alagumalai, K.; Kim, S.-C. Preparation and Performance of Biodegradable Poly(butylene adipate-co-terephthalate) Composites Reinforced with Novel AgSnO2 Microparticles for Application in Food Packaging. Polymers 2023, 15, 554. [Google Scholar] [CrossRef]
- Venkatesan, R.; Alagumalai, K.; Raorane, C.J.; Raj, V.; Shastri, D.; Kim, S.-C. Morphological, Mechanical, and Antimicrobial Properties of PBAT/Poly(methyl methacrylate-co-maleic anhydride)–SiO2 Composite Films for Food Packaging Applications. Polymers 2023, 15, 101. [Google Scholar] [CrossRef]
- Venkatesan, R.; Vanaraj, R.; Alagumalai, K.; Asrafali, S.P.; Raorane, C.J.; Raj, V.; Kim, S.-C. Thermoplastic Starch Composites Reinforced with Functionalized POSS: Fabrication, Characterization, and Evolution of Mechanical, Thermal and Biological Activities. Antibiotics 2022, 11, 1425. [Google Scholar] [CrossRef] [PubMed]
- ASTM D638-14; Standard Test Method for Tensile Properties of Plastics. ASTM International: West Conshohocken, PA, USA, 2022.
- ASTM D3985-17; Standard Test Method for Oxygen Gas Transmission Rate through Plastic Film and Sheeting Using a Coulometric Sensor. ASTM International: West Conshohocken, PA, USA, 2022.
- ASTM F1249-90; Standard Test Method for Water Vapor Transmission Rate through Plastic Film and Sheeting Using a Modulated Infrared Sensor. ASTM International: West Conshohocken, PA, USA, 2022.
- Sundaram, I.M.; Kalimuthu, S.; Ponniah, G. Highly active ZnO modified g-C3N4 Nanocomposite for dye degradation under UV and Visible Light with enhanced stability and antimicrobial activity. Compos. Commun. 2017, 5, 64–71. [Google Scholar] [CrossRef]
- Dewi, R.; Agusnar, H.; Alfian, Z. Tamrin Characterization of technical kaolin using XRF, SEM, XRD, FTIR and its potentials as industrial raw materials. J. Phys. Conf. Ser. 2018, 1116, 042010. [Google Scholar] [CrossRef]
- Venkatesan, R.; Rajeswari, N. TiO2 nanoparticles/poly(butylene adipate-co-terephthalate) bionanocomposite films for packaging applications. Polym. Adv. Technol. 2017, 28, 1699–1706. [Google Scholar] [CrossRef]
- Venkatesan, R.; Rajeswari, N. ZnO/PBAT nanocomposite films: Investigation on the mechanical and biological activity for food packaging. Polym. Adv. Technol. 2017, 28, 20–27. [Google Scholar] [CrossRef]
- Balaji, S.; Venkatesan, R.; Mugeeth, L.; Dhamodharan, R. Hydrophobic nanocomposites of PBAT with Cl- fn -POSS nanofiller as compostable food packaging films. Polym. Eng. Sci. 2021, 61, 314–326. [Google Scholar] [CrossRef]

| SiO2 | Al2O3 | Fe2O3 | MgO | K2O | CaO | TiO2 | LOI a |
|---|---|---|---|---|---|---|---|
| 47.85 | 37.60 | 0.83 | 0.17 | 0.97 | 0.57 | 0.74 | 11.27 |
| S. No | Sample Name | PBAT Pellets (wt%) | Kaolin Clay (wt%) |
|---|---|---|---|
| 1. | PBC-0.0 | 100.0 | 0.0 |
| 2. | PBC-1.0 | 99.0 | 1.0 |
| 3. | PBC-2.0 | 98.0 | 2.0 |
| 4. | PBC-3.0 | 97.0 | 3.0 |
| 5. | PBC-5.0 | 95.0 | 5.0 |
Disclaimer/Publisher’s Note: The statements, opinions and data contained in all publications are solely those of the individual author(s) and contributor(s) and not of MDPI and/or the editor(s). MDPI and/or the editor(s) disclaim responsibility for any injury to people or property resulting from any ideas, methods, instructions or products referred to in the content. |
© 2023 by the authors. Licensee MDPI, Basel, Switzerland. This article is an open access article distributed under the terms and conditions of the Creative Commons Attribution (CC BY) license (https://creativecommons.org/licenses/by/4.0/).
Share and Cite
Venkatesan, R.; Alagumalai, K.; Kim, S.-C. Preparation and Antimicrobial Characterization of Poly(butylene adipate-co-terephthalate)/Kaolin Clay Biocomposites. Polymers 2023, 15, 1710. https://doi.org/10.3390/polym15071710
Venkatesan R, Alagumalai K, Kim S-C. Preparation and Antimicrobial Characterization of Poly(butylene adipate-co-terephthalate)/Kaolin Clay Biocomposites. Polymers. 2023; 15(7):1710. https://doi.org/10.3390/polym15071710
Chicago/Turabian StyleVenkatesan, Raja, Krishnapandi Alagumalai, and Seong-Cheol Kim. 2023. "Preparation and Antimicrobial Characterization of Poly(butylene adipate-co-terephthalate)/Kaolin Clay Biocomposites" Polymers 15, no. 7: 1710. https://doi.org/10.3390/polym15071710
APA StyleVenkatesan, R., Alagumalai, K., & Kim, S.-C. (2023). Preparation and Antimicrobial Characterization of Poly(butylene adipate-co-terephthalate)/Kaolin Clay Biocomposites. Polymers, 15(7), 1710. https://doi.org/10.3390/polym15071710








